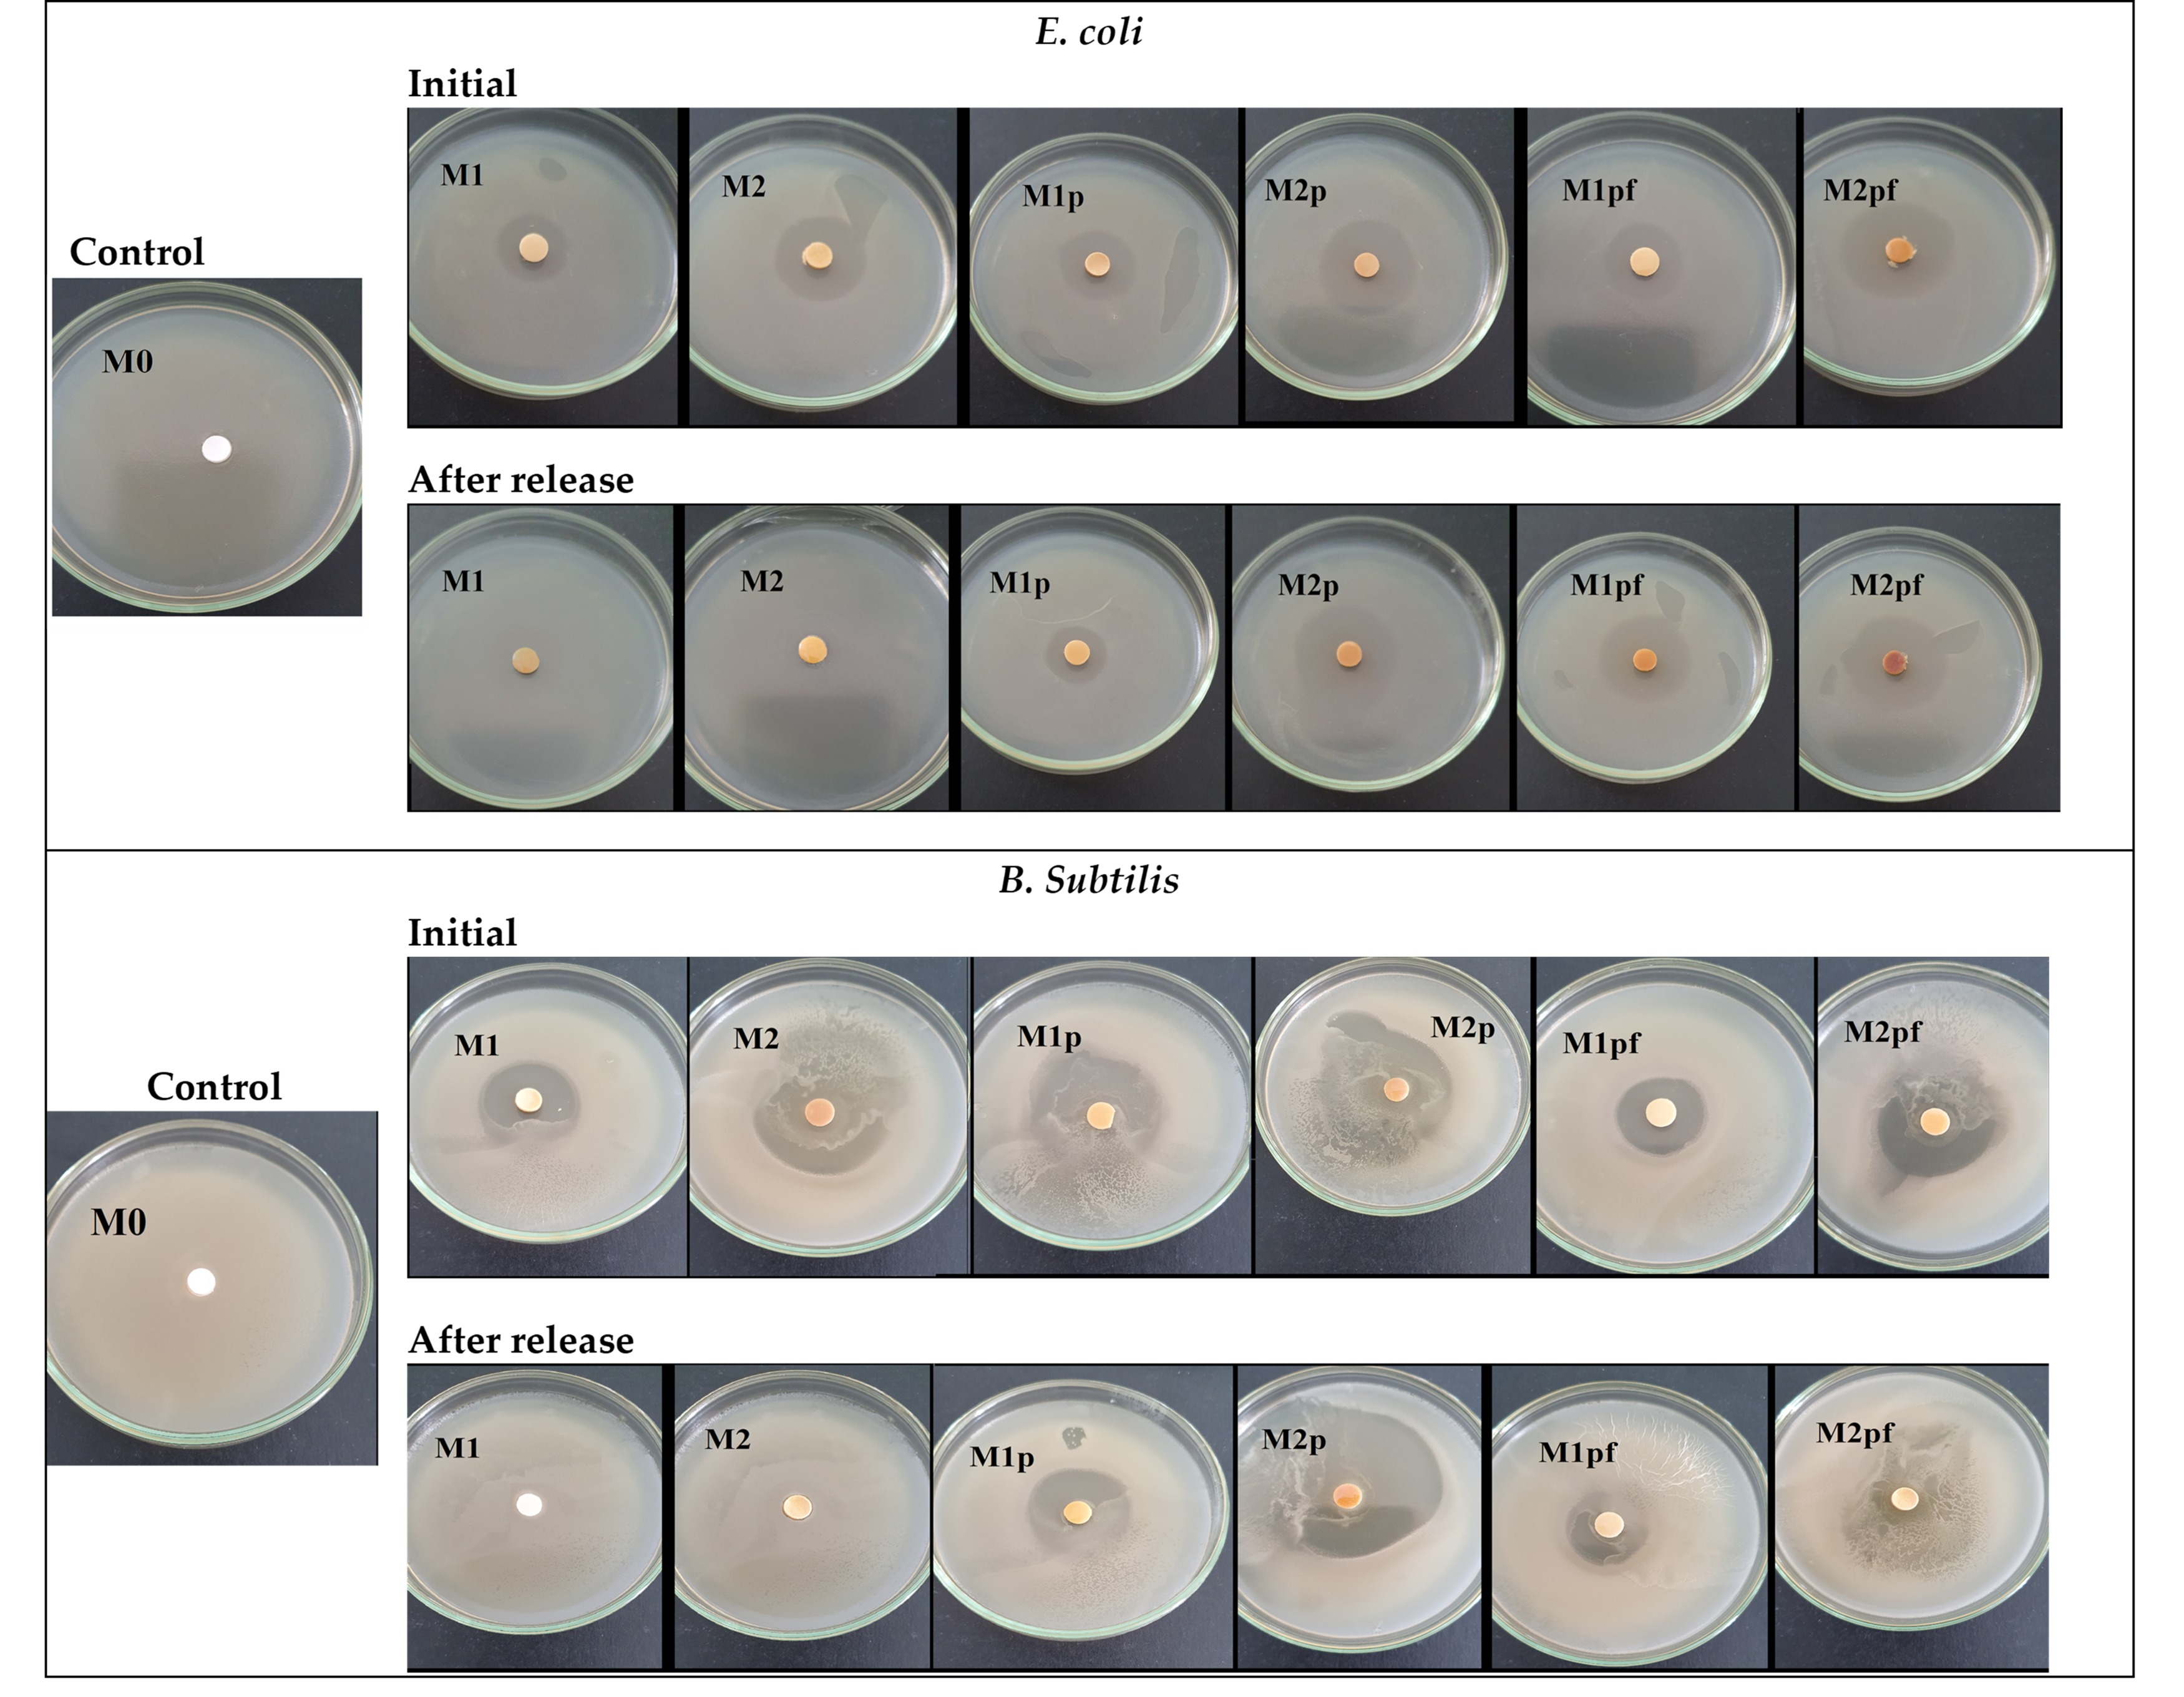
Applsci 13 01015 g004

Bacterial Cellulose–Polyvinyl Alcohol Based Complex Composites for Controlled Drug Release
Abstract
Featured Application
Abstract
1. Introduction
2. Materials and Methods
2.1. Materials
2.2. Composites Preparation
2.3. Composites Characterization
2.4. Drug Release Studies
2.5. Antibacterial Activity
3. Results and Discussions
4. Conclusions
Author Contributions
Funding
Informed Consent Statement
Data Availability Statement
Conflicts of Interest
References
- Lee, E.J.; Huh, B.K.; Kim, S.N.; Lee, J.Y.; Park, C.G.; Mikos, A.G.; Choy, Y.B. Application of Materials as Medical Devices with Localized Drug Delivery Capabilities for Enhanced Wound Repair. Prog. Mater. Sci. 2017, 89, 392–410. [Google Scholar] [CrossRef] [PubMed]
- Ulker Turan, C.; Metin, A.; Guvenilir, Y. Controlled Release of Tetracycline Hydrochloride from Poly(ω-Pentadecalactone-Co-ε-Caprolactone)/Gelatin Nanofibers. Eur. J. Pharm. Biopharm. 2021, 162, 59–69. [Google Scholar] [CrossRef] [PubMed]
- Patil, P.P.; Reagan, M.R.; Bohara, R.A. Silk Fibroin and Silk-Based Biomaterial Derivatives for Ideal Wound Dressings. Int. J. Biol. Macromol. 2020, 164, 4613–4627. [Google Scholar] [CrossRef] [PubMed]
- Ghafoor, B.; Aleem, A.; Najabat Ali, M.; Mir, M. Review of the Fabrication Techniques and Applications of Polymeric Electrospun Nanofibers for Drug Delivery Systems. J. Drug Deliv. Sci. Technol. 2018, 48, 82–87. [Google Scholar] [CrossRef]
- Tamahkar, E. Bacterial Cellulose/Poly Vinyl Alcohol Based Wound Dressings with Sustained Antibiotic Delivery. Chem. Pap. 2021, 75, 3979–3987. [Google Scholar] [CrossRef]
- Tamahkar, E.; Özkahraman, B.; Süloğlu, A.K.; İdil, N.; Perçin, I. A Novel Multilayer Hydrogel Wound Dressing for Antibiotic Release. J. Drug Deliv. Sci. Technol. 2020, 58, 101536. [Google Scholar] [CrossRef]
- Shao, W.; Liu, H.; Wang, S.; Wu, J.; Huang, M.; Min, H.; Liu, X. Controlled Release and Antibacterial Activity of Tetracycline Hydrochloride-Loaded Bacterial Cellulose Composite Membranes. Carbohydr. Polym. 2016, 145, 114–120. [Google Scholar] [CrossRef] [PubMed]
- Wan, W.-K.; Millon, L. (54) Poly(vinyl Alcohol)—Bacterial Cellulose Nanocomposite. Available online: https://patents.google.com/patent/WO2005016397A1/ja (accessed on 28 December 2022).
- Wang, C.; Bai, J.; Tian, P.; Xie, R.; Duan, Z.; Lv, Q.; Tao, Y. The Application Status of Nanoscale Cellulose-Based Hydrogels in Tissue Engineering and Regenerative Biomedicine. Front. Bioeng. Biotechnol. 2021, 9, 732513. [Google Scholar] [CrossRef] [PubMed]
- Swingler, S.; Gupta, A.; Gibson, H.; Kowalczuk, M.; Heaselgrave, W.; Radecka, I. Recent Advances and Applications of Bacterial Cellulose in Biomedicine. Polymers 2021, 13, 412. [Google Scholar] [CrossRef]
- Emre Oz, Y.; Keskin-Erdogan, Z.; Safa, N.; Esin Hames Tuna, E. A Review of Functionalised Bacterial Cellulose for Targeted Biomedical Fields. J. Biomater. Appl. 2021, 36, 648–681. [Google Scholar] [CrossRef]
- Urbina, L.; Corcuera, M.Á.; Gabilondo, N.; Eceiza, A.; Retegi, A. A Review of Bacterial Cellulose: Sustainable Production from Agricultural Waste and Applications in Various Fields. Cellulose 2021, 28, 8229–8253. [Google Scholar] [CrossRef]
- Choi, S.M.; Rao, K.M.; Zo, S.M.; Shin, E.J.; Han, S.S. Bacterial Cellulose and Its Applications. Polymers 2022, 14, 1080. [Google Scholar] [CrossRef] [PubMed]
- Khan, S.; Ul-Islam, M.; Ullah, M.W.; Zhu, Y.; Narayanan, K.B.; Han, S.S.; Park, J.K. Fabrication Strategies and Biomedical Applications of Three-Dimensional Bacterial Cellulose-Based Scaffolds: A Review. Int. J. Biol. Macromol. 2022, 209, 9–30. [Google Scholar] [CrossRef] [PubMed]
- Lokhande, P.E.; Singh, P.P.; Vo, D.-V.N.; Kumar, D.; Balasubramanian, K.; Mubayi, A.; Srivastava, A.; Sharma, A. Bacterial Nanocellulose: Green Polymer Materials for High Performance Energy Storage Applications. J. Environ. Chem. Eng. 2022, 10, 108176. [Google Scholar] [CrossRef]
- Manan, S.; Ullah, M.W.; Ul-Islam, M.; Shi, Z.; Gauthier, M.; Yang, G. Bacterial Cellulose: Molecular Regulation of Biosynthesis, Supramolecular Assembly, and Tailored Structural and Functional Properties. Prog. Mater. Sci. 2022, 129, 100972. [Google Scholar] [CrossRef]
- Navya, P.V.; Gayathri, V.; Samanta, D.; Sampath, S. Bacterial Cellulose: A Promising Biopolymer with Interesting Properties and Applications. Int. J. Biol. Macromol. 2022, 220, 435–461. [Google Scholar] [CrossRef]
- Jabbari, F.; Babaeipour, V.; Bakhtiari, S. Bacterial Cellulose-Based Composites for Nerve Tissue Engineering. Int. J. Biol. Macromol. 2022, 217, 120–130. [Google Scholar] [CrossRef] [PubMed]
- Volova, T.G.; Prudnikova, S.V.; Kiselev, E.G.; Nemtsev, I.V.; Vasiliev, A.D.; Kuzmin, A.P.; Shishatskaya, E.I. Bacterial Cellulose (BC) and BC Composites: Production and Properties. Nanomaterials 2022, 12, 192. [Google Scholar] [CrossRef]
- Jipa, I.; Stoica, A.; Stroescu, M.; Dobre, L.-M.; Dobre, T.; Jinga, S.; Tardei, C. Potassium Sorbate Release from Poly(Vinyl Alcohol)-Bacterial Cellulose Films. Chem. Pap. 2012, 66, 138–143. [Google Scholar] [CrossRef]
- Voicu, G.; Jinga, S.-I.; Drosu, B.-G.; Busuioc, C. Improvement of Silicate Cement Properties with Bacterial Cellulose Powder Addition for Applications in Dentistry. Carbohydr. Polym. 2017, 174, 160–170. [Google Scholar] [CrossRef]
- Das, S.; Subuddhi, U. Controlled Delivery of Ibuprofen from Poly(Vinyl Alcohol)–poly(Ethylene Glycol) Interpenetrating Polymeric Network Hydrogels. J. Pharm. Anal. 2019, 9, 108–116. [Google Scholar] [CrossRef]
- Wahid, F.; Wang, F.-P.; Xie, Y.-Y.; Chu, L.-Q.; Jia, S.-R.; Duan, Y.-X.; Zhang, L.; Zhong, C. Reusable Ternary PVA Films Containing Bacterial Cellulose Fibers and ε-Polylysine with Improved Mechanical and Antibacterial Properties. Colloids Surf. B Biointerfaces 2019, 183, 110486. [Google Scholar] [CrossRef] [PubMed]
- Savencu, I.; Iurian, S.; Porfire, A.; Bogdan, C.; Tomuță, I. Review of Advances in Polymeric Wound Dressing Films. React. Funct. Polym. 2021, 168, 105059. [Google Scholar] [CrossRef]
- Busuioc, C.; Isopencu, G.; Banciu, A.; Banciu, D.-D.; Oprea, O.; Mocanu, A.; Deleanu, I.; Zăuleţ, M.; Popescu, L.; Tănăsuică, R.; et al. Bacterial Cellulose Hybrid Composites with Calcium Phosphate for Bone Tissue Regeneration. IJMS 2022, 23, 16180. [Google Scholar] [CrossRef]
- Jipa, I.M.; Stoica-Guzun, A.; Stroescu, M. Controlled Release of Sorbic Acid from Bacterial Cellulose Based Mono and Multilayer Antimicrobial Films. LWT 2012, 47, 400–406. [Google Scholar] [CrossRef]
- Dobre, L.-M.; Stoica-Guzun, A.; Stroescu, M.; Jipa, I.; Dobre, T.; Ferdeş, M.; Ciumpiliac, Ş. Modelling of Sorbic Acid Diffusion through Bacterial Cellulose-Based Antimicrobial Films. Chem. Pap. 2012, 66, 144–151. [Google Scholar] [CrossRef]
- Chunshom, N.; Chuysinuan, P.; Techasakul, S.; Ummartyotin, S. Dried-State Bacterial Cellulose (Acetobacter Xylinum) and Polyvinyl-Alcohol-Based Hydrogel: An Approach to a Personal Care Material. J. Sci. Adv. Mater. Devices 2018, 3, 296–302. [Google Scholar] [CrossRef]
- Zhang, L.; Zheng, S.; Hu, Z.; Zhong, L.; Wang, Y.; Zhang, X.; Xue, J. Preparation of Polyvinyl Alcohol/Bacterial-Cellulose-Coated Biochar–Nanosilver Antibacterial Composite Membranes. Appl. Sci. 2020, 10, 752. [Google Scholar] [CrossRef]
- Shen, X.L.; Wu, J.M.; Chen, Y.; Zhao, G. Antimicrobial and Physical Properties of Sweet Potato Starch Films Incorporated with Potassium Sorbate or Chitosan. Food Hydrocoll. 2010, 24, 285–290. [Google Scholar] [CrossRef]
- Limpan, N.; Prodpran, T.; Benjakul, S.; Prasarpran, S. Properties of Biodegradable Blend Films Based on Fish Myofibrillar Protein and Polyvinyl Alcohol as Influenced by Blend Composition and PH Level. J. Food Eng. 2010, 100, 85–92. [Google Scholar] [CrossRef]
- Su, J.-F.; Huang, Z.; Zhao, Y.-H.; Yuan, X.-Y.; Wang, X.-Y.; Li, M. Moisture Sorption and Water Vapor Permeability of Soy Protein Isolate/Poly(Vinyl Alcohol)/Glycerol Blend Films. Ind. Crops Prod. 2010, 31, 266–276. [Google Scholar] [CrossRef]
- Guiga, W.; Swesi, Y.; Galland, S.; Peyrol, E.; Degraeve, P.; Sebti, I. Innovative Multilayer Antimicrobial Films Made with Nisaplin® or Nisin and Cellulosic Ethers: Physico-Chemical Characterization, Bioactivity and Nisin Desorption Kinetics. Innov. Food Sci. Emerg. Technol. 2010, 11, 352–360. [Google Scholar] [CrossRef]
- Postelnicescu, P.; Dumitrescu, A.M.; Danciu, T.D. Kinetic Studies on the Controlled Release of Oral Antibiotics. Rev. Chim. 2015, 4, 1545. [Google Scholar]
- So, G.C.; Macdonald, D.G. Kinetics of Oil Extraction from Canola (Rapeseed). Can. J. Chem. Eng. 1986, 64, 80–86. [Google Scholar] [CrossRef]
- Balouiri, M.; Sadiki, M.; Ibnsouda, S.K. Methods for in Vitro Evaluating Antimicrobial Activity: A Review. J. Pharm. Anal. 2016, 6, 71–79. [Google Scholar] [CrossRef]
- Wen, Y.; Yu, B.; Zhu, Z.; Yang, Z.; Shao, W. Synthesis of Antibacterial Gelatin/Sodium Alginate Sponges and Their Antibacterial Activity. Polymers 2020, 12, 1926. [Google Scholar] [CrossRef]
- Türe, H. Characterization of Hydroxyapatite-Containing Alginate–Gelatin Composite Films as a Potential Wound Dressing. Int. J. Biol. Macromol. 2019, 123, 878–888. [Google Scholar] [CrossRef]
- Zhong, T.; Jiang, Z.; Wang, P.; Bie, S.; Zhang, F.; Zuo, B. Silk Fibroin/Copolymer Composite Hydrogels for the Controlled and Sustained Release of Hydrophobic/Hydrophilic Drugs. Int. J. Pharm. 2015, 494, 264–270. [Google Scholar] [CrossRef]
- Nanjwade, B.K.; Bechra, H.M.; Derkar, G.K.; Manvi, F.V.; Nanjwade, V.K. Dendrimers: Emerging Polymers for Drug-Delivery Systems. Eur. J. Pharm. Sci. 2009, 38, 185–196. [Google Scholar] [CrossRef] [PubMed]
- Cazón, P.; Vázquez, M.; Velazquez, G. Composite Films with UV-Barrier Properties of Bacterial Cellulose with Glycerol and Poly(Vinyl Alcohol): Puncture Properties, Solubility, and Swelling Degree. Biomacromolecules 2019, 20, 3115–3125. [Google Scholar] [CrossRef] [PubMed]
- Koosehgol, S.; Ebrahimian-Hosseinabadi, M.; Alizadeh, M.; Zamanian, A. Preparation and Characterization of in Situ Chitosan/Polyethylene Glycol Fumarate/Thymol Hydrogel as an Effective Wound Dressing. Mater. Sci. Eng. C 2017, 79, 66–75. [Google Scholar] [CrossRef] [PubMed]
- Jenvoraphot, T.; Thapsukhon, B.; Daranarong, D.; Molloy, R.; Supanchart, C.; Krisanaprakornkit, S.; Topham, P.D.; Tighe, B.; Mahomed, A.; Punyodom, W. Tetracycline-Loaded Electrospun Poly( l-Lactide-Co-ε-Caprolactone) Membranes for One-Step Periodontal Treatment. ACS Appl. Polym. Mater. 2022, 4, 2459–2469. [Google Scholar] [CrossRef]
- Hashemi Doulabi, A.; Mirzadeh, H.; Imani, M.; Samadi, N. Chitosan/Polyethylene Glycol Fumarate Blend Film: Physical and Antibacterial Properties. Carbohydr. Polym. 2013, 92, 48–56. [Google Scholar] [CrossRef] [PubMed]
- Cazón, P.; Velázquez, G.; Vázquez, M. Characterization of Bacterial Cellulose Films Combined with Chitosan and Polyvinyl Alcohol: Evaluation of Mechanical and Barrier Properties. Carbohydr. Polym. 2019, 216, 72–85. [Google Scholar] [CrossRef]
- Jipa, I.M.; Dobre, L.; Stroescu, M.; Stoica-Guzun, A.; Jinga, S.; Dobre, T. Preparation and Characterization of Bacterial Cellulose-Poly(Vinyl Alcohol) Films with Antimicrobial Properties. Mater. Lett. 2012, 66, 125–127. [Google Scholar] [CrossRef]
- Song, S.; Liu, Z.; Abubaker, M.A.; Ding, L.; Zhang, J.; Yang, S.; Fan, Z. Antibacterial Polyvinyl Alcohol/Bacterial Cellulose/Nano-Silver Hydrogels That Effectively Promote Wound Healing. Mater. Sci. Eng. C 2021, 126, 112171. [Google Scholar] [CrossRef] [PubMed]
- Raimundini Aranha, A.C.; de Matos Jorge, L.M.; Nardino, D.A.; Casagrande Sipoli, C.; Suzuki, R.M.; Dusman Tonin, L.T.; Oliveira Defendi, R. Modelling of Bioactive Components Extraction from Corn Seeds. Chem. Eng. Res. Des. 2021, 175, 339–347. [Google Scholar] [CrossRef]
- Das, I.; Arora, A. Kinetics and Mechanistic Models of Solid-Liquid Extraction of Pectin Using Advance Green Techniques—A Review. Food Hydrocoll. 2021, 120, 106931. [Google Scholar] [CrossRef]
- Rayo-Mendez, L.M.; Koshima, C.C.; Pessoa Filho, P.A.; Tadini, C.C. Recovery of Non-Starch Polysaccharides from Ripe Banana (Musa Cavendishii). J. Food Eng. 2021, 292, 110356. [Google Scholar] [CrossRef]
- Karuppuswamy, P.; Reddy Venugopal, J.; Navaneethan, B.; Luwang Laiva, A.; Ramakrishna, S. Polycaprolactone Nanofibers for the Controlled Release of Tetracycline Hydrochloride. Mater. Lett. 2015, 141, 180–186. [Google Scholar] [CrossRef]
- Silhavy, T.J.; Kahne, D.; Walker, S. The Bacterial Cell Envelope. Cold Spring Harb. Perspect. Biol. 2010, 2, a000414. [Google Scholar] [CrossRef] [PubMed]

| Sample ID | Structure | Composition | Blending Ratio (w/w) * | Thickness (mm) | Drug Loading mg/g d.m. |
|---|---|---|---|---|---|
| M0 | monolayer (control) | PVA, NpBC | 7, 2.3 | 0.479 ± 0.395 | NA |
| M1 | monolayer | PVA, NpBC, TC-HCl | 7, 2.3, 0.1 | 0.481 ± 0.121 | 10.60 |
| M2 | monolayer | PVA, NpBC, TC-HCl | 7, 2.3, 0.5 | 0.523 ± 0.158 | 50.86 |
| M1p | 3-layer | PVA/M1/PVA | 7/7, 2.3, 0.1/7 | 0.756 ± 0.142 | 7.73 |
| M2p | 3-layer | PVA/M2/PVA | 7/7, 2.3, 0.5/7 | 0.785 ± 0.155 | 35.71 |
| M1pf | 3-layer | PVA, NfBC/M1/PVA, NfBC | 7, 1.75/7, 2.3, 0.1/7, 1.75 | 0.793 ± 0.151 | 7.24 |
| M2pf | 3-layer | PVA, NfBC/M2/PVA, NfBC | 7, 1.75/7, 2.3, 0.5/7, 1.75 | 0.817 ± 0.148 | 35.20 |
| Sample ID | SD (%) | WS (%) | WVTR (g m−2 day−1) | WVP·109 (g m−1 s−1 Pa−1) | D (m2 s−1) | R2 | cw | cd | kw | kd | R2 |
|---|---|---|---|---|---|---|---|---|---|---|---|
| M1 | 4.06 ± 0.15 | 29.80 ± 1.32 | 271.21 ± 5.63 | 0.65 ± 0.03 | 1.045·10−13 | 0.965 | 4.5 | 5.81 | 9.5·10−4 | 5.8·10−5 | 0.989 |
| M2 | 3.92 ± 0.31 | 32.44 ± 2.14 | 255.16 ± 7.59 | 0.61 ± 0.06 | 1.029·10−13 | 0.992 | 10.5 | 12.6 | 6.5·10−4 | 5.5·10−5 | 0.985 |
| M1p | 5.65 ± 0.41 | 36.15 ± 2.32 | 420.05 ± 9.76 | 1.59 ± 0.14 | 1.357·10−13 | 0.930 | 1.7 | 3.05 | 8.5·10−5 | 7.2·10−6 | 0.988 |
| M2p | 5.42 ± 0.35 | 38.69 ± 1.59 | 387.31 ± 4.95 | 1.52 ± 0.09 | 1.851·10−13 | 0.858 | 4.8 | 11.08 | 8.5·10−5 | 1.9·10−5 | 0.992 |
| M1pf | 4.35 ± 0.37 | 25.35 ± 1.21 | 597.38 ± 7.53 | 2.37 ± 0.08 | 3.31·10−13 | 0.989 | 1.4 | 3.6 | 3.1·10−5 | 6.8·10−6 | 0.987 |
| M2pf | 4.12 ± 0.28 | 26.48 ± 1.35 | 583.21 ± 6.51 | 2.38 ± 0.11 | 5.22·10−13 | 0.890 | 4.3 | 8.8 | 4.8·10−5 | 1.8·10−5 | 0.990 |
| Sample ID | Inhibition Zone (mm) | |||
|---|---|---|---|---|
| E. coli | B. subtilis | |||
| Initial | After Release | Initial | After Release | |
| M0 (control) | 0 | - | 0 | - |
| M1 | 5.6 ± 0.2 | 0.7 ± 0.2 | 8.7 ± 0.35 | 0.8 ± 0.2 |
| M2 | 9.2 ± 0.4 | 0.5 ± 0.1 | 14.0 ± 0.9 | 1.0 ± 0.2 |
| M1p | 6 ± 0.3 | 5 ± 0.1 | 11 ± 0.4 | 8 ± 0.2 |
| M2p | 10.5 ± 0.2 | 12 ± 0.2 | 13 ± 0.6 | 15 ± 0.45 |
| M1pf | 5 ± 0.3 | 8 ± 0.2 | 3.7 ± 0.2 | 6.6 ± 0.23 |
| M2pf | 10.6 ± 0.25 | 9.5 ± 0.35 | 8.7 ± 0.18 | 12 ± 0.45 |
Disclaimer/Publisher’s Note: The statements, opinions and data contained in all publications are solely those of the individual author(s) and contributor(s) and not of MDPI and/or the editor(s). MDPI and/or the editor(s) disclaim responsibility for any injury to people or property resulting from any ideas, methods, instructions or products referred to in the content. |
© 2023 by the authors. Licensee MDPI, Basel, Switzerland. This article is an open access article distributed under the terms and conditions of the Creative Commons Attribution (CC BY) license (https://creativecommons.org/licenses/by/4.0/).
Share and Cite
Busuioc, C.; Isopencu, G.O.; Deleanu, I.-M. Bacterial Cellulose–Polyvinyl Alcohol Based Complex Composites for Controlled Drug Release. Appl. Sci. 2023, 13, 1015. https://doi.org/10.3390/app13021015
Busuioc C, Isopencu GO, Deleanu I-M. Bacterial Cellulose–Polyvinyl Alcohol Based Complex Composites for Controlled Drug Release. Applied Sciences. 2023; 13(2):1015. https://doi.org/10.3390/app13021015
Chicago/Turabian StyleBusuioc, Cristina, Gabriela Olimpia Isopencu, and Iuliana-Mihaela Deleanu. 2023. "Bacterial Cellulose–Polyvinyl Alcohol Based Complex Composites for Controlled Drug Release" Applied Sciences 13, no. 2: 1015. https://doi.org/10.3390/app13021015
APA StyleBusuioc, C., Isopencu, G. O., & Deleanu, I.-M. (2023). Bacterial Cellulose–Polyvinyl Alcohol Based Complex Composites for Controlled Drug Release. Applied Sciences, 13(2), 1015. https://doi.org/10.3390/app13021015

